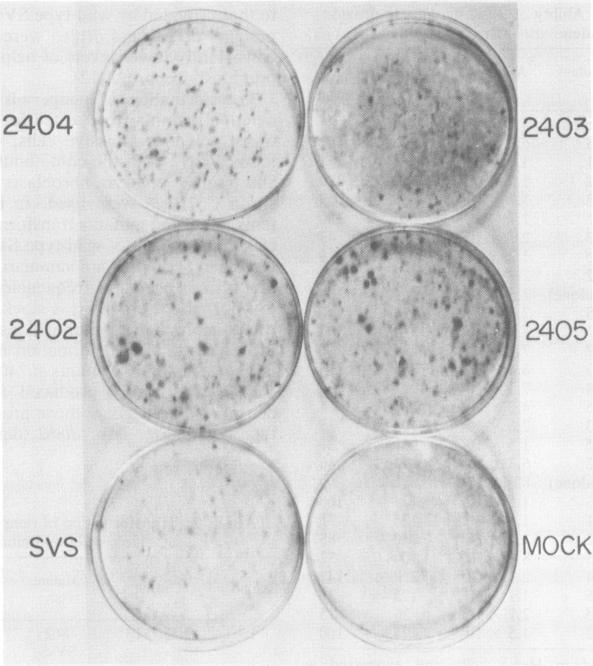

猿猴病毒40早期区域3'端附近序列缺失的存活缺失突变体的构建与鉴定。
Construction and characterization of viable deletion mutants of simian virus 40 lacking sequences near the 3' end of the early region.
作者信息
Polvino-Bodnar M, Cole C N
出版信息
J Virol. 1982 Aug;43(2):489-502. doi: 10.1128/JVI.43.2.489-502.1982.
Five viable deletion mutants of simian virus 40 (SV40) were prepared and characterized. These mutants lack 15 to 60 base pairs between map positions 0.198 and 0.218, near the 3' end of the early region of SV40 and extend further into the body of the A gene, encoding the large T antigen, than previously described deletion mutants. These mutants were isolated after transfection of monkey kidney CV-1p cells with full-sized linear DNA prepared by partial digestion of form I SV40 DNA with restriction endonucleases HinfI or MboII, followed by removal of approximately 25 base pairs of DNA from the 5' termini using lambda-5'-exonuclease and purification of the DNA in agarose gels. Based on camparisons of the DNA sequence of SV40 and polyoma virus, these mutations map in the 19% of the SV40 A gene that shares no homology with the A gene of polyoma virus. The mutations exist in two different genetic backgrounds: the original set of mutants (dl2401 through dl2405) was prepared, using as a parent SV40 mutant dl862, which has a deletion at the single HpaII site (0.725 map unit). A second set (dl2491 through dl2495) contains the same deletions in a wild-type SV40 (strain SV-S) background. Relative to wild-type SV40, the original mutants showed reduced rates of growth, lower yields of progeny virus and viral DNA, and smaller plaque size; in these properties the mutants resembled parental dl862, although mutant progeny yields were usually lower than yields of dl862, suggesting a possible interaction between the two deletions. The second set of mutants had growth properties and progeny yields similar to those of wild-type SV40; however, Southern blotting experiments indicated that viral DNA replication proceeds at a slightly reduced rate. All of the mutants transformed mouse NIH/3T3 cells and mouse embryo fibroblasts at the same frequency as wild-type SV40. Mutants dl2402, dl2492, and dl2405 consistently produced denser and larger foci in both types of cells. All mutants directed the synthesis of shortened large T antigens. Adenovirus helper function was retained by all mutants.
制备并鉴定了猿猴病毒40(SV40)的五个存活缺失突变体。这些突变体在SV40早期区域3'端附近的图谱位置0.198至0.218之间缺失15至60个碱基对,并且比先前描述的缺失突变体更深入地延伸到编码大T抗原的A基因主体中。这些突变体是在用限制性内切酶HinfI或MboII部分消化I型SV40 DNA制备的全长线性DNA转染猴肾CV-1p细胞后分离得到的,随后使用λ-5'-外切核酸酶从5'末端去除约25个碱基对的DNA,并在琼脂糖凝胶中纯化DNA。基于SV40和多瘤病毒DNA序列的比较,这些突变位于SV40 A基因中与多瘤病毒A基因无同源性的19%区域。这些突变存在于两种不同的遗传背景中:最初的一组突变体(dl2401至dl2405)是以SV40突变体dl862为亲本制备的,dl862在单个HpaII位点(0.725图谱单位)有缺失。第二组(dl2491至dl2495)在野生型SV40(SV-S株)背景中具有相同的缺失。相对于野生型SV40,最初的突变体生长速率降低,子代病毒和病毒DNA产量降低,噬斑尺寸变小;在这些特性上,突变体类似于亲本dl862,尽管突变体子代产量通常低于dl862,这表明两个缺失之间可能存在相互作用。第二组突变体的生长特性和子代产量与野生型SV40相似;然而,Southern印迹实验表明病毒DNA复制速率略有降低。所有突变体以与野生型SV40相同的频率转化小鼠NIH/3T3细胞和小鼠胚胎成纤维细胞。突变体dl2402、dl2492和dl2405在两种类型的细胞中始终产生更密集和更大的病灶。所有突变体都指导合成缩短的大T抗原。所有突变体都保留了腺病毒辅助功能。